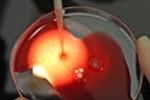
Неустроенная личная жизнь заставляет женщин все чаще выбирать ЭКО

Тег: Чаще

На Ставрополье в ДТП всё чаще попадают пожилые водители
Госавтоинспекция края бьет тревогу: на Ставрополье увеличилось количество ДТП, виновниками которых становятся люди пожилого возраста...

Ставропольский адвокат считает статью об оскорблении чувств верующих противоречащей Конституции
Ставропольский адвокат Андрей Сабинин, представляющий интересы блогера Виктора Краснова, просит проверить статью 148 УК РФ («Оскорбление чувств верующ...

Ставропольцы всё чаще впадают в депрессию из-за кризиса
Как показал опрос «Левада-центра», экономический кризис серьёзно отразился на самочувствии и настроении россиян. Составленный социологами индекс полож...

Жители Ставрополья имеют право выбора лечащего врача
Как сообщил директор Территориального фонда обязательного медицинского страхования края Сергей Трошин на брифинге в региональном правительстве, ежегод...

На Ставрополье всё чаще происходят происшествия на воде
С наступлением жары на Ставрополье наблюдается тенденция к увеличению количества жертв неправильного отдыха на воде. Руководство федеральных, краевых...

В адрес администрации Ставрополя стали чаще поступать благодарности
В администрации краевого центра проанализировали работу с обращениями граждан. За шесть месяцев в мэрию города поступило более 4 700 обращений. Горо...

Медики советуют чаще выходить в свет и записаться в кружки по лепке и рисованию
Люди среднего и пожилого возраста, которые ходят в кружки творчества и рукоделия, тем самым, ограждают себя от ухудшения памяти и мыслительных способ...

Материнский капитал ставропольцы чаще всего тратят на жилье
Свыше 59 тысяч семей направили средства материального капитала на улучшение жилищных условий – это больше половины от общего количества получивших вып...

Жители Пятигорска и Лермонтова чаще всего сталкиваются с коррупцией
Временно исполняющий обязанности губернатора Владимир Владимиров провёл первое заседание краевого межведомственного Совета по противодействию коррупци...

В Ставрополе чаще всего похищают «Ладу» и «ВАЗ»
С января по май 2014 года в Ставрополе было совершено 44 угона автомобилей. Из них 19 были раскрыты. Как показывает анализ, преступления данного вида,...

Управление ЗАГС: На Ставрополье стали чаще жениться и рожать
Управление записи актов гражданского состояния населения Ставрополья подвело итоги работы за прошлый год. В целом ЗАГС отмечает улучшение показател...

9 причин, для того чтобы чаще есть картошку
Диетологи утверждают, что картофель это не только вкусное дополнение к нашему меню, но и источник многих полезных веществ для организма...

Молодежь Азербайджана стала чаще сталкиваться с инфарктом
Заболевания кровеносной системы в Азербайджане являются наиболее распространенными, как и во всем мире. В прошлом году число страдающих от таких болез...

Испанские ученые советуют чаще употреблять томатный соус
Ученые из Университета Барселоны установили, что включение в рацион соуса софрито, который включает в себя томаты, лук, чеснок, кукурузную муку и оли...

Жители Ставрополья стали реже умирать и чаще рожать
Позитивным итогом истекших семи месяцев 2013 года стал естественный прирост населения в Ставропольском крае, сообщает краевой комитет по массовым комм...

Дмитрий Дибров все чаще думает о смерти
53-летний шоумен и музыкант Дмитрий Дибров ведет очень активную личную жизнь. Как известно, около четырех лет назад он связал себя узами брака в четве...

Дети стали чаще звонить по «Детскому телефону доверия»
В министерстве социальной защиты населения Ставропольского края обсудили эффективность деятельности на территории края «Детского телефона доверия» с е...

Врачи не рекомендуют мыться чаще двух раз в неделю
Мыться слишком часто не очень полезно, особенно с использованием таких популярных средств, как жидкое мыло, предупреждают израильские врачи...

Какие женщины чаще набирают вес
Ученые австралийского Центра медицинской экономики при университете Монаш считают, что набор избыточного веса у женщин связан, как правило, с нездоров...

В Ставрополе чаще других угоняют автомобили марки «Лада-Приора»
С начала этого года в краевом центре были угнаны 16 автомобилей, и только шесть из них найдены и возвращены владельцам. По словам начальника ОГИБДД Уп...

Уральские туристы все чаще бронируют авиабилеты онлайн
В истиннее время наблюдается рост самостоятельного бронирования авиабилетов. При этом, стоит отметить, что Уральский федеральный округ на 30% превысил...

В Ставрополе стартует Первая школа актива учащейся молодежи края
Сейчас, 26 августа, в 16.30 в молодежном таборе «Лесная поляна» раскрывается 1-ая школа актива учащейся молодежи края «Достижения», которая станет еди...

Капитал, заработанный на Форексе, все чаще переводят в драгметаллы
Длится тенденция роста котировок драгоценных металлов на глобальных биржах. Форекс трейдеры все почаще решают перевести капитал в драгоценные сплавы.В...

Россияне стали чаще покупать товары в кредит
Граждане Русской Федерации все почаще отдают предпочтение покупке продуктов в кредит. При этом, брать кредит в банках они отрицаются, в связи с высоки...

Туристы все чаще отказываются от отелей в пользу съемных апартаментов в Риме
Туристы, отправляющиеся в странствие в сказочную Италию, в первую очередь, устремляются посетить Рим, ведь это – один из самых знаменитых и примечател...
Неустроенная личная жизнь заставляет женщин все чаще выбирать ЭКО
Растущее число одиноких дам, которые так и не отыскали свою "вторую половинку", но желают деток, восоздает доп нагрузку на репродуктологов, предлаг...

Ставропольцы стали чаще ездить на электричках
За восемь месяцев этого года число обитателей и гостей края, воспользовавшихся услугами пригородного жд транспорта, подросло практически на 11 процент...

Дети из "замороженной пробирки" чаще рождаются с отклонениями от нормы
Дети, родившиеся из замороженных эмбрионов вследствие ЭКО, чаще по размеру превосходят норму. Вероятность наличия повышенного веса увеличивается в 1,6...

Какую технику чаще всего приобретают?
Всероссийский центр изучения общественного мнения (ВЦИОМ) в ходе недавнего исследования, в котором преследовалась цель узнать, какая бытовая техника с...

Родившиеся весной дети чаще страдают от анорексии
Дети, родившиеся весной, имеют больше шансов на развитие нервной анорексии, в отличие от родившихся осенью, обнаружили исследователи...

Женщины чаще занимаются самолечением
Ученые из Испании выяснили, что гораздо чаще лекарства без предписания врача принимают женщины. Также, склонность заниматься самолечением зависит от н...

Оральный секс вызывает рак чаще, чем табак и алкоголь
Основной причиной раковых заболеваний горла и ротовой полости у людей моложе 50 лет стал вирус, передаваемый во время орального секса...

При домашних родах дети умирают вдвое чаще
Американские ученые пришли к выводу, что риск смерти ребенка при домашних родах вдвое превышает риск при рождении в роддоме.Как сообщает Би-би-си, в х...